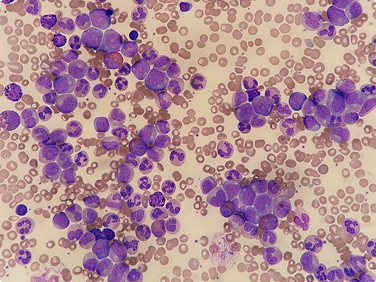

Are your lab test results really “normal”?
Discover the secrets hidden in your blood work that your "normal" results won't tell you about.
Discover the
secrets hidden in your blood work
that your "normal" results
won't tell you about.
Watch the video to understand why your 'normal' lab tests could be hiding real health issues.
Risk-Free Purchase: Enjoy a 7-day unconditional guarantee. Get instant access after payment confirmation.
I know you never thought you'd have to learn how to read your own lab tests...
If you’re like most people, you probably rely on your doctor to interpret the results of your lab tests, which contain a wealth of information about your health—if they know how to interpret it.
But most of the time, all we hear is that everything is “normal”.
If deep down, you can’t shake the feeling that there’s more to the story, that your body is not lying to you, then this Masterclass is for you.
I know you never thought you'd have to learn how to read your own lab tests...
If you’re like most people, you probably rely on your doctor to interpret the results of your lab tests, which contain a wealth of information about your health—if they know how to interpret it.
But most of the time, all we hear is that everything is “normal”.
But is it? Is everything really normal?
If deep down, you can’t shake the feeling that there’s more to the story, that your body is not lying to you, then this Masterclass is for you.
This Masterclass is based on my book
"Your Lab Test Results EXPLAINED"

But it goes way deeper.
In over 50 lessons, I break down the most important markers of a basic lab report, starting with the foundation of any health investigation: your Complete Blood Count (CBC).
You’ll uncover clues in your bloodwork that most doctors overlook, from gut parasites to subclinical thyroid issues that hide behind “normal” results. You’ll also understand the connection between hidden nutritional deficiencies and your blood chemistry—insights you won’t find in a simple Google search, making this Masterclass truly invaluable.
Beyond learning the optimal values for lab tests, you’ll discover the critical tests you actually need (even if your doctor won’t order them). And this is power.
Now, here’s where things get even more exciting…
You’ll learn something that most doctors don’t know: the secret ratios that reveal the real state of your health. Once you understand these formulas, you’ll never look at lab tests the same way again.
And perhaps the most liberating truth?
You’ll finally have peace of mind knowing that high cholesterol means nothing out of context and that LDL is a terrible predictor of heart disease.
It’s time for the truth to come to light. And it’s your right to know all of this.
In this Masterclass, you will learn:
GET THE MASTERCLASS TODAY...
And secure your exclusive bonus!

The ultimate list of lab tests
Get the complete list of lab tests your doctor should be ordering for you, which offers crucial insights into your metabolic health, nutritional status, and overall well-being.

Decode the Hidden Ratios of Your Lab Results
Learn the secret formulas that reveal the true state of your health.
WHY, AMIDST SO MANY DOCTORS TELLING YOU YOUR RESULTS ARE NORMAL, SHOULD YOU TRUST ME?
Because I understand that “normal” isn’t the same as “optimal.”
Even if your lab results fall within the normal range, a detailed analysis can reveal critical insights doctors often overlook.
Let’s be honest — doctors are trained to react when your results are abnormal, not to dig deep when you’re seemingly fine.
But instead of waiting for illness to strike, I teach you how to:
Decipher your lab test results at home, even if you have no medical background.
For the past 7 years, I’ve helped people from 17+ countries uncover the real story behind their health and find authentic, natural healing.
- I've guided women once labeled "infertile" to conceive naturally.
- I've helped individuals with severe eczema clear their skin without medication.
- I've empowered people to reverse insulin resistance, heal their fatty liver, and shed stubborn belly fat— all naturally.
I know what it takes to heal from the inside out, and it starts with understanding the language of your blood work.
You’re one step away from learning how to read your results like a pro.
And you’re about to access the most comprehensive Masterclass that costs just a fraction of what traditional medical programs charge.

Déborah is a creative health & wellness consultant with over 11 years of experience in designing and delivering disruptive, integrative physical and digital experiences in the health, wellness & hospitality sector.
- Bachelor of Science in Nursing from the prestigious University of São Paulo, in 2011.
- Certifications from the most renowned American schools of Neuro-Linguistic Programming, Emotional Intelligence and Holistic Nutrition.
- Coaching Instructor and Student Mentor at Institute for Integrative Nutrition (IIN).
- Writer of health & wellness articles to newspapers in the UAE, like The National and Gulf News.
- Author of "Your Lab Test Results EXPLAINED".
WHY, AMIDST SO MANY DOCTORS TELLING YOU YOUR RESULTS ARE NORMAL, SHOULD YOU TRUST ME?
WHY, AMIDST SO MANY DOCTORS TELLING YOU YOUR RESULTS ARE NORMAL, SHOULD YOU TRUST ME?
Because I understand that “normal” isn’t the same as “optimal.”
Even if your lab results fall within the normal range, a detailed analysis can reveal critical insights doctors often overlook.
Let’s be honest — doctors are trained to react when your results are abnormal, not to dig deep when you’re seemingly fine.
But instead of waiting for illness to strike, I teach you how to:
Decipher your lab test results at home, even if you have no medical background.
For the past 7 years, I’ve helped people from 17+ countries uncover the real story behind their health and find authentic, natural healing.
- I've guided women once labeled "infertile" to conceive naturally.
- I've helped individuals with severe eczema clear their skin without medication.
- I've empowered people to reverse insulin resistance, heal their fatty liver, and shed stubborn belly fat— all naturally.
I know what it takes to heal from the inside out, and it starts with understanding the language of your blood work.
You’re one step away from learning how to read your results like a pro.
And you’re about to access the most comprehensive Masterclass that costs just a fraction of what traditional medical programs charge.

Déborah is a creative health & wellness consultant with over 11 years of experience in designing and delivering disruptive, integrative physical and digital experiences in the health, wellness & hospitality sector.
- Bachelor of Science in Nursing from the prestigious University of São Paulo, in 2011.
- Certifications from the most renowned American schools of Neuro-Linguistic Programming, Emotional Intelligence and Holistic Nutrition.
- Coaching Instructor and Student Mentor at Institute for Integrative Nutrition (IIN).
- Writer of health & wellness articles to newspapers in the UAE, like The National and Gulf News.
- Author of "Your Lab Test Results EXPLAINED".
Frequently Asked Questions
This Masterclass is for anyone who wants to take control of their health by understanding their own lab test results. Whether you're dealing with unexplained fatigue, stubborn weight gain, digestive issues, hormone imbalances, or "weird" symptoms, this course will give you the tools to uncover what’s really going on in your body.
Not at all! The Masterclass is designed for everyday people, not just healthcare professionals. I break down complex concepts into simple, easy-to-understand lessons so you can confidently analyze your lab results.
Google can give you fragments of information, but it won’t show you how to connect the dots or interpret your results in the context of your overall health. In this Masterclass, I’ll teach you the secret ratios and patterns that even most doctors don’t check, giving you a complete, functional medicine approach to your lab tests.
Once you enroll, you have immediate access to the Masterclass. Which means that from day 1, you can already start studying and applying what you’re learning.
Yes, I do offer consultations. Please email deborahvitorino@gmail.com with a brief description of your needs and request a consultation with Deborah.
Once you enroll, you get one-year access to all lessons and materials, so you can revisit them whenever you need.
You’ll have access to a private community where you can ask questions, share your results, and get support from me and other students.
You can buy it on Amazon.com.
Copyright © 2023 Deborah Vitorino | All Rights Reserved